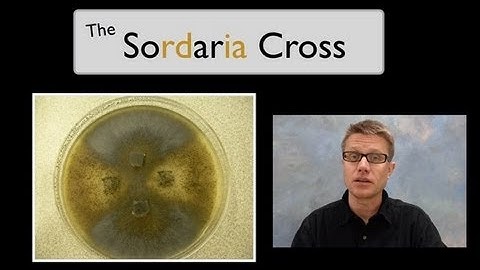
The Sordaria Cross

⬇ DOWNLOAD NOW
Kalau muncul iklan pop-up, tutup lalu klik tombol kembali
Download lagu For Double Haploid Crosses and Recombinant Inbred Lines and Backcross F1 Crosses secara gratis hanya untuk keperluan promosi. Dukung artis favorit kamu dengan membeli musik original di iTunes atau platform resmi lainnya.
 How seed breeding works
How seed breeding works
 Doubled Haploid Wheat Production
Doubled Haploid Wheat Production
 Making Wheat Doubled Haploids.wmv
Making Wheat Doubled Haploids.wmv
 unequal crossing over
unequal crossing over
 Hybridization vs Inbreeding
Hybridization vs Inbreeding
 11 USLGE Heterosis and Crossbreeding
11 USLGE Heterosis and Crossbreeding
 Recombinant Inbred Line ( RILs) population development in Maize
Recombinant Inbred Line ( RILs) population development in Maize
The Sordaria Cross
The Sordaria Cross